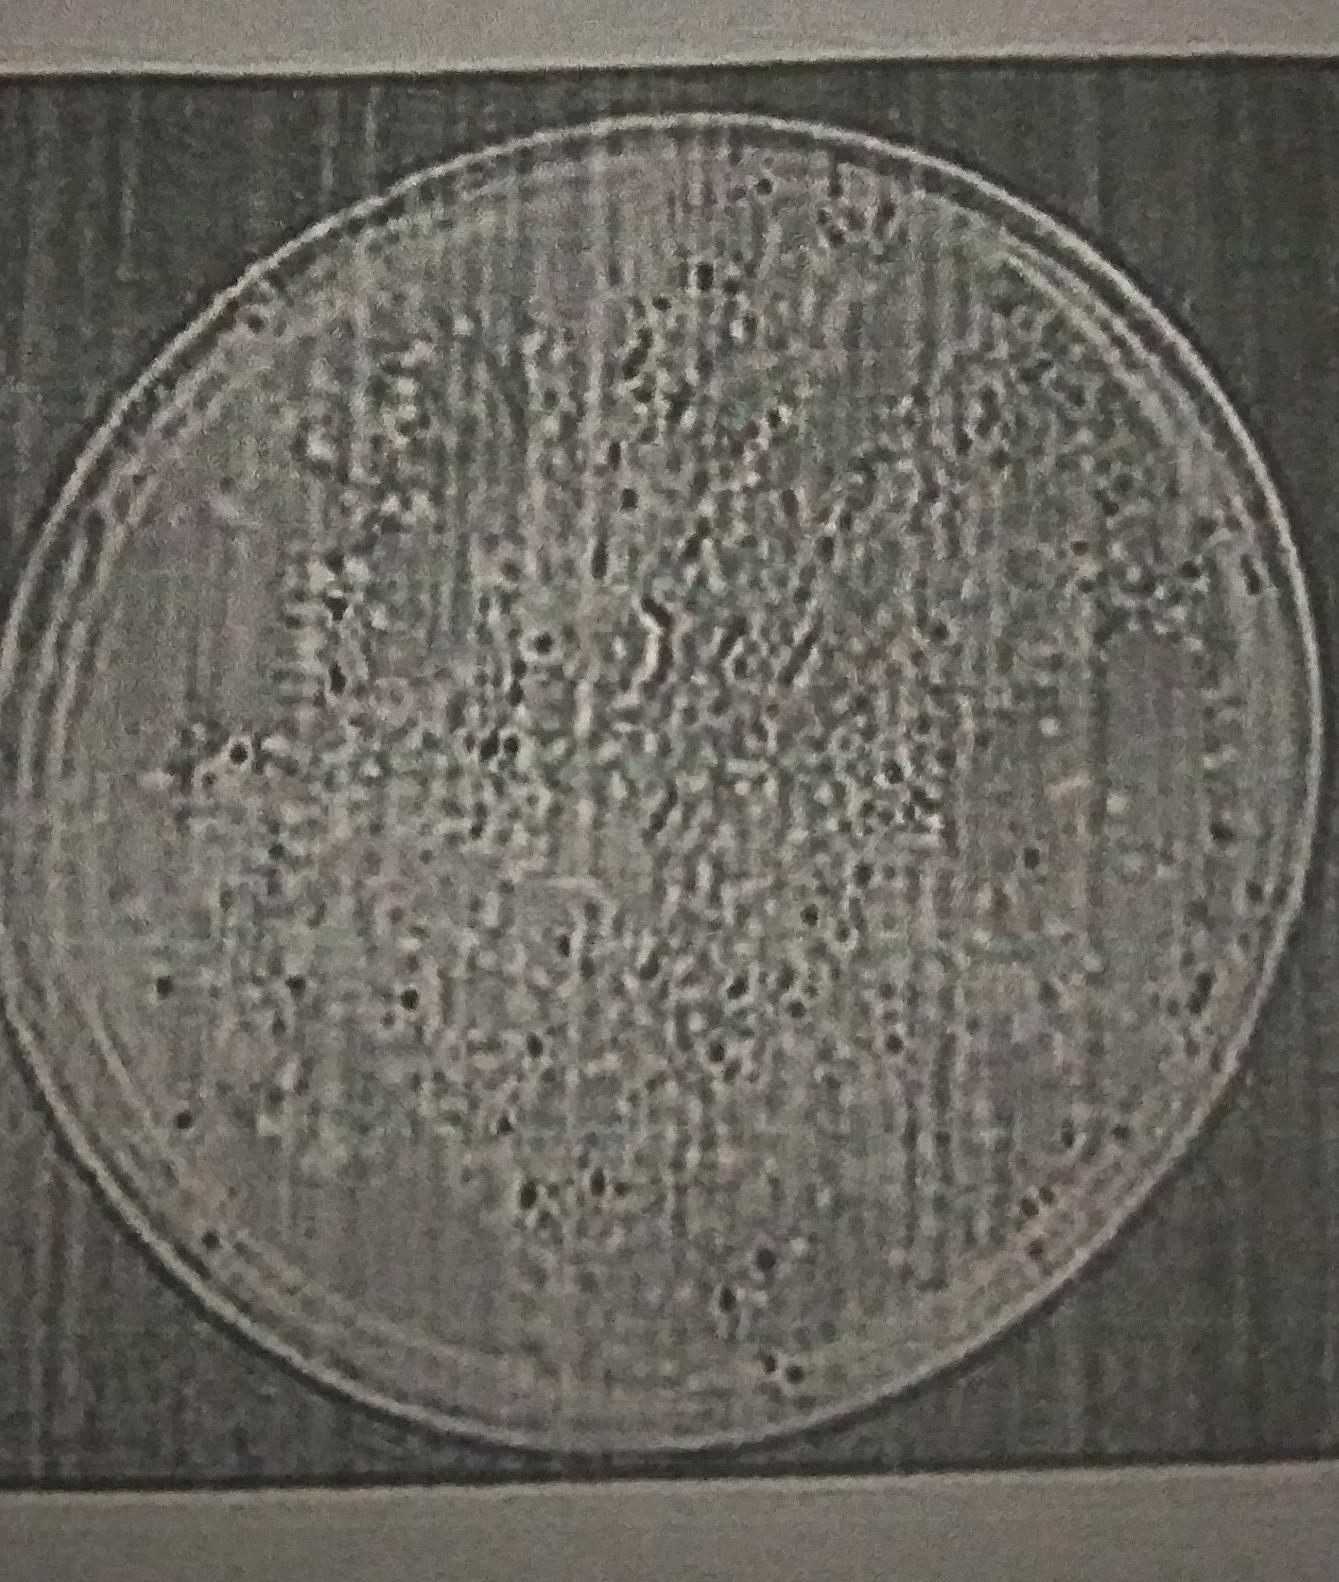

Как называется раздел биологии, объектом изученя
которого являются изображённые на фотографии
объекты?
1) микробиология
2) зоология
3) ботаника
4) вирусология
Объясните свой ответ с использованием знаний об объектах изучения биологи.
Приложения:
Ответы
Ответ дал:
0
Ответ:
На этой картинке ничего не понятно, но я думаю, что это либо микробиология, которая занимается изучением клеток, или вирусоология, потому что это могут быть вирусы. Но это точно не растения и не животные, соответственно зоология и ботаника отпадают. На рисунке видно, что это маленькие одноклеточные организмы.
Ответ дал:
4
Ответ:
1)микробология
Объяснение:
микробиология – наука о микроорганизмах.На фотографии изображены колонии бактерий, а наука, которая изучает микроскопические организмы, называется микробиология.
думаю правильно
Аноним:
спасибо
Вас заинтересует
2 года назад
2 года назад
2 года назад
8 лет назад
8 лет назад